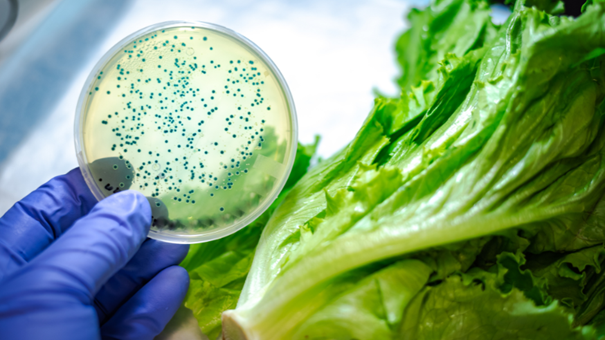

*patogen – (Grško: pathos – bolečina) – infekciozni agens – klica – mikrob ali mikroorganizem (npr. virus, bakterija, prion), ki povzroča bolezen. Mikroorganizmi: bakterije, virusi, kvasovke, plesni, alge, parazitski protozoji, mikroskopski parazitski helminti ter njihovi toksini in metaboliti.
Živila so že kot surovine onesnažena z mikroorganizmi. Do nadaljnjega onesnaženja pa pride pri proizvodnji in prometu z živili. Kjer koli imajo ljudje opravka z živili, obstaja tudi možnost okužbe s človeškimi patogenimi mikroorganizmi. Navzkrižno onesnaženje živil pomeni prenos mikroorganizmov na živila preko drugih živil, kuhinjskega pribora in opreme, naprav pri industrijski proizvodnji ter preko oseb, ki živila pripravljajo. Tudi glodalci, muhe in drugi insekti ter ptiči lahko prenašajo mikroorganizme na živila. Svoj delež mikroorganizmov prispevajo tudi zrak, prah, voda in najrazličnejši aditivi. S preprečevanjem navzkrižnega onesnaženja živil preprečujemo možnost okužb in zastrupitev in posledično zmanjšujemo možnost nastanka črevesnih nalezljivih bolezni.
Uvodoma omenjamo najprej onesnaženje z zemljo, z vodo in zrakom, potem pa bomo opisali še onesnaženje posameznih vrst živil.
Onesnaženje z zemljo
Zemlja vsebuje največ raznovrstnih mikroorganizmov, s katerimi se lahko onesnažijo rastline in živali. Veter raznaša prah z zemlje, ki pride v vodo in tudi v živila. Vsi pomembni onesnaževalci živil so v zemlji; predvsem razne vrste plesni in kvasovk ter vrste bakterij iz rodov oziroma skupin Bacillus, Clostridium, Aerobacter, Escherichia, Micrococcus, Alcaligenes, Achromobacter, Flavobacterium, Proteus, Streptococcus, Acetobacter…. S pranjem z rastlin odstranimo veliko zemlje in prahu. Če zalivamo z odpadno vodo, je zelo verjetno, da bomo onesnažili tudi rastline, ki jih uživamo surove. Nanje bodo prešle patogene bakterije, posebno tiste, ki povzročajo črevesne bolezni.
Onesnaženje z vodo
Naravne vode ne vsebujejo samo naravne mikroflore, ampak tudi mikroorganizme, ki prehajajo vanje iz zemlje, živali ter odpadnih voda. Površinska voda rek in stoječa voda jezer in ribnikov precej variirata glede količine mikroorganizmov; po nevihti jih je več tisoč v 1 ml, drugače pa jih je relativno malo, ker se voda sama čisti. Voda, ki prihaja iz izvirov in je šla skozi razne zemeljske plasti, nima veliko mikroorganizmov (od nekaj do nekaj sto v ml). Vrste bakterij v naravnih vodah so iz rodov in skupin Pseudomonas, Chromobacterium, Proteus, Achromobacter, Micrococcus, Bacillus, Aerobacter in Escherichia; bakterije zadnjih treh skupin verjetno niso del naravne flore. Voda, ki jo uporabljajo v proizvodnji živil mora ustrezati bakteriološkim standardom za pitno vodo. Z neustrezno oz. oporečno vodo se lahko onesnažijo mnoga živila, kadar jo uporabljamo npr. za pranje živil, za hlajenje (koliformne in druge škodljive bakterije), za proizvodnjo ledu itd.
Onesnaženje iz zraka
Zrak nima svoje »naravne« mikroflore; vsi mikroorganizmi pridejo v zrak s trdnih snovi ali dežnih kapelj. Mikroorganizmi pridejo v zrak s prahom, iz suhe zemlje, iz kapljic kadar kašljamo, kihamo ali govorimo. Vir mikroorganizmov pa so lahko tudi tla in stene objektov za proizvodnjo živil. Mikroorganizmi v zraku nimajo pogojev za rast in razmnoževanje; tam najdlje vztrajajo tisti, ki so najbolj odporni proti izsušitvi. V zraku je vedno veliko spor plesni, ker so odporne proti izsušitvi. Število mikroorganizmov v zraku je odvisno od svetlobe, vlage, lokacije, gibanja in količine prahu ali kapljic. Suh zrak ima običajno manj mikroorganizmov kot vlažen. Dež in sneg očistita zrak tako, da po dežju v zraku praktično ni mikroorganizmov.